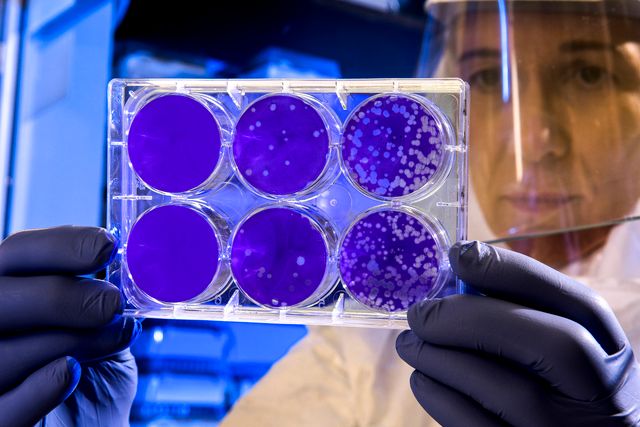
Коли може початись масова вакцинація проти коронавірусу - фото 416545

На вказану електронну адресу було надіслано повідомлення для підтвердження реєстрації
Коли може початись масова вакцинація проти коронавірусу
- 272
У Всесвітній організації охорони здоров'я припустили, коли у світі може стартувати масова вакцинація проти COVID-19, адже вже зараз тестують чимало видів вакцин. Детальніше читайте далі.
Заступник очільника ВООЗ Сумія Свамінатан повідомила, що очікувати на масову вакцинацію проти коронавірусу можна буде вже з середини 2021 року. Річ у тому, що вже зараз більше як 20 вакцин на стадії клінічних випробувань, тож частина з них можуть спрацювати.
До теми: Новини про коронавірус в Україні: скільки хворих на Covid-19 станом на 20 липня
Дослідники зможуть отримати результати випробувань вже на початку 2021 року, тому й дата масової вакцинації припадає на літо. Варто додати, що хоч антитіла до коронавірусу через деякий час можуть зникати, але це не можна вважати доказом відсутності набутого імунітету.
Тим часом учені з Королівського коледжу Лондона вважають, що коронавірус може викликати 6 основних форм захворювання, кожна з яких відрізняється симптомами і допомагає медикам визначити, чи можливі ризики появи серйозних ускладнень зі здоров'ям.
Читайте також: Сифіліс не винен: учені вважають, що Рафаель помер від одного з видів коронавірусу
Цей матеріал має винятково інформаційний характер і не містить жодних порад, діагнозів чи висновків, що стосуються вашого здоров'я. Якщо вам потрібні встановлення діагнозу, консультація медика або лікування, зверніться до фахівця.
- 30 червня
-
21:23Яке свято відзначають 1 липня: традиції, заборони і прикмети на цей день
-
21:00Чому павербанк не можна класти у валізу: авіаексперти попереджають про небезпеку
-
21:00Ліниві кабачкові чебуреки – літня вечеря, яка підкорює з першого шматочка
-
20:00Чотири знаки зодіаку, яким 1 липня доведеться імпровізувати: гороскоп дня
-
19:15Чорний чай замість мийного засобу: несподіваний спосіб повернути блиск дерев'яній підлозі
-
 Українські патріотичні пісні: плейлист, який підіймає дух
Українські патріотичні пісні: плейлист, який підіймає дух
-
19:00У липні буде кілька хвиль магнітних бур: чи будуть сильні та до чого варто готуватись
-
18:35П'ять знаків зодіаку, які майже ніколи не приховують правду
-
17:45Жир у трубах більше не проблема – три прості способи прочистити раковину
-
17:30Для затишних і теплих вечорів: добірка книжок, які варто прочитати цього літа
-
17:05Сини Брітні Спірс дебютували на подіумі під час Паризького тижня моди
-
17:00Робота на городі у самому розпалі: коли варто виходити на город у липні, а коли – ні
-
16:10"Зможу прожити": солістка гурту "Лісапетний батальйон" назвала розмір своєї пенсії
-
15:00На огірках не з’являється зав’язь: досвідчені городники назвали головні причини
-
 З Днем народження: топ 75 привітань у картинках, віршах, прозі та смс українською
З Днем народження: топ 75 привітань у картинках, віршах, прозі та смс українською
-
14:00Як приготувати малиновий сорбет вдома: простий рецепт
-
13:00Що взяти на пікнік: список речей, без яких відпочинок на природі може зіпсуватися
-
12:00Педикюр без лаку набирає популярності: чому “голі” нігті стали головним трендом літа 2026
-
11:00Еко-декор із природних матеріалів: 5 стильних ідей, які зроблять оселю затишнішою
-
10:00Що буде, якщо їсти кавун щодня: дієтологиня перевірила на собі та назвала результати
-
09:00Одна помилка – і троянди швидко зів’януть: як правильно доглядати за букетом у вазі
-
08:02Як обрати постільну білизну, яка зробить спальню затишнішою
-
05:30Зірки назвали 4 знаки, яким 30 червня варто довіритися інтуїції більше, ніж логіці
- 29 червня
-
21:22Яке свято відзначають 30 червня: традиції, заборони і прикмети на цей день
-
18:20Аналітики спрогнозували, наскільки можуть подорожчати нові iPhone 18 Pro
- 30 червня
-
21:23Яке свято відзначають 1 липня: традиції, заборони і прикмети на цей день
-
19:00У липні буде кілька хвиль магнітних бур: чи будуть сильні та до чого варто готуватись
-
17:30Для затишних і теплих вечорів: добірка книжок, які варто прочитати цього літа
-
17:05Сини Брітні Спірс дебютували на подіумі під час Паризького тижня моди
-
17:00Робота на городі у самому розпалі: коли варто виходити на город у липні, а коли – ні
-
13:00Що взяти на пікнік: список речей, без яких відпочинок на природі може зіпсуватися
-
09:00Одна помилка – і троянди швидко зів’януть: як правильно доглядати за букетом у вазі
-
05:30Зірки назвали 4 знаки, яким 30 червня варто довіритися інтуїції більше, ніж логіці
- 29 червня
-
21:22Яке свято відзначають 30 червня: традиції, заборони і прикмети на цей день
-
17:10Charli XCX випустила новий сингл Wink Wink і показала провокативний кліп
-
17:00Дефіцит дощів і рекордна спека: чого чекати від найспекотнішого місяця року
-
13:00Розріжте лимон і встроміть у нього гвоздику: простий спосіб, який допоможе позбутися мух
-
09:00Солоні огірки допомагають худнути: який ефект вони мають та що радять дієтологи
-
05:30Місяць у Близнюках: три знаки Зодіаку отримають у понеділок інформацію, яка все змінює
- 28 червня
-
21:22Яке свято відзначають 29 червня: традиції, заборони і прикмети на цей день
-
18:00Як врятуватися у спеку: жителька Єгипту озвучила несподівані лайфхаки
-
14:00Як охолодитись у спекотний день: прості та дієві поради для кожного
-
10:00День Конституції України 2026: цікаві факти про цю дату
-
05:30Сонце в Раку, Місяць у Тельці: найтепліший і найзатишніший день червня вже сьогодні
- 27 червня
-
21:22Яке свято відзначають 28 червня: традиції, заборони і прикмети на цей день
-
17:10Усик оголосив про відмову від усіх чемпіонських поясів: чи завершує боксер кар'єру
-
17:00Навіть не думайте йти до перукаря у ці дні липня: експерименти зі стрижкою проваляться
-
13:00Яку каву найкраще пити на сніданок: вчені назвали спосіб приготування
-
09:00Недосип змушує їсти більше солодкого: вчені пояснили, як сон впливає на тягу до цукру
-
05:30Субота під знаком Овна: три знаки Зодіаку отримають шанс, який не можна пропустити







